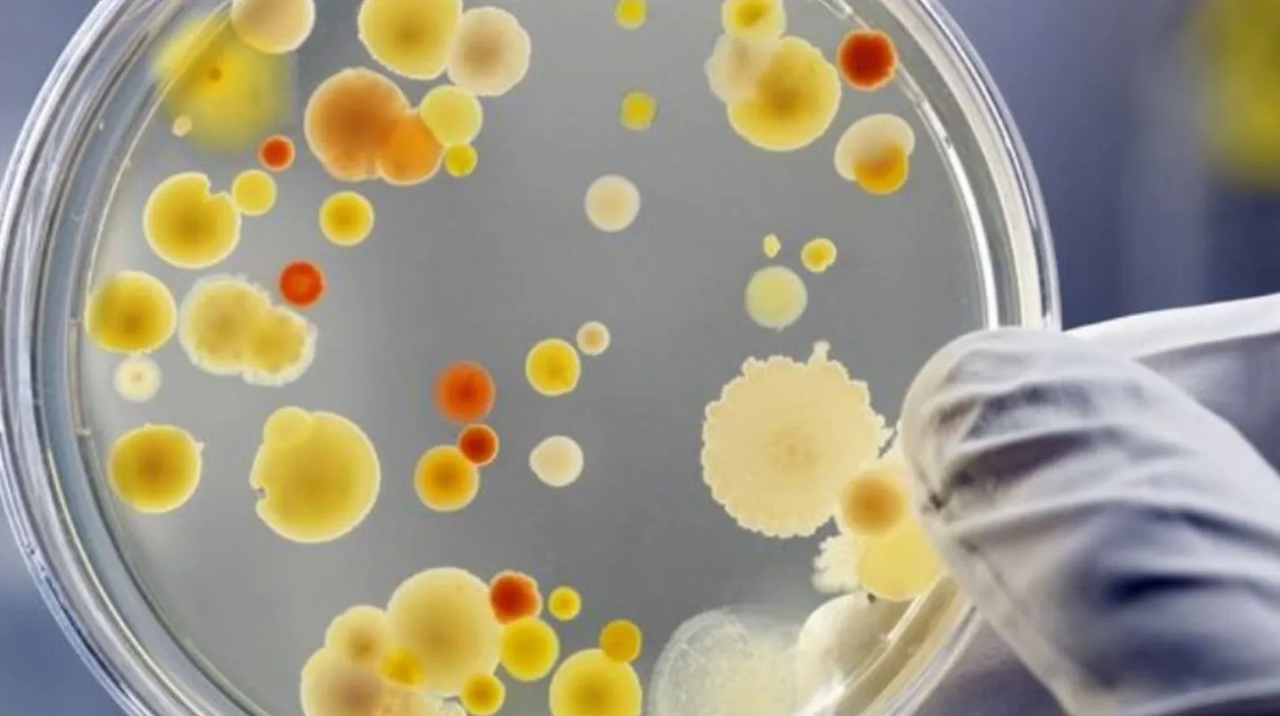
Hongo pone en alerta a los Estados Unidos; es superresistente y mortal

Cándida Auris, microorganismo superresistente a los medicamentos y potencialmente mortal ha puesto en alerta a los Estados Unidos porque las infecciones han crecido dramáticamente.
Estos contagios se dieron entre los años 2019 y 2021, de acuerdo con un estudio que se publicó este lunes por medio de la revista especializada Annals of Internal Medicine.
las noticias, vamos a darte información acerca de este hongo, los contagios y cuáles son las consecuencias de su existencia.
Los investigadores, en concreto, alertaron por el aumento de casos que son resistentes a la equinocandinas, fármaco principal en el tratamiento de las infecciones por el hongo Cándida.
Esta clase de casos fueron más frecuentes en el año 2021 que en los años anteriores de acuerdo con el estudio, mismo que hizo la labor de analizar datos de los Centros para el Control y la Prevención de Enfermedades (CDC) asà como los recogidos por las autoridades de salud a nivel local y estatal.
Estos datos muestran el aumento del porcentaje de crecimiento de las infecciones con Cándida Auris que pasó de ser del 44% en 2019 al 95% en el año 2021.
De acuerdo con los investigadores que trabajan para los CDC, el aumento pudo relacionarse con la pandemia de Covid-19, y se relaciona con las dificultades de ésta, y etsas son la escasez de sanitarios o el uso de más medicinas antimicrobianos.
El informe enfatiza que el Cándida auris, que fue detectado en Estados Unidos en el año 2016, se católica como ‘amenaza urgente’ por los CDC por su resistencia a los medicamentos y a su alta tasa de mortalidad, más de 1 de cada 3 pacientes mueren dentro del mes de haber recibido el diagnóstico de una infección invasiva por C.
auris.
Twitter para mantenerte informado con las noticias de hoy.
SÃguenos en Facebook y entérate de las noticias trend de la semana
No hay comentarios.:
Publicar un comentario